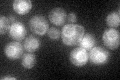
YLR034C
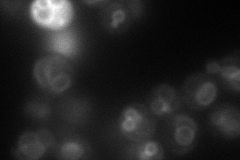
YLR034C
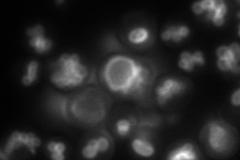
YLR034C
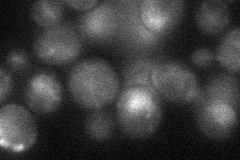
YLR034C
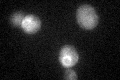
YLR034C

View description
Putative divalent metal ion transporter involved in iron homeostasis; transcriptionally regulated by metal ions; member of the Nramp family of metal transport proteins
Localization:
Intensity:
Fold change:
Significance:
-
C’ GFP library in SD
ER44.46 -
N' NOP1pr-GFP in SD
vacuole membrane78.6854 -
N' TEF2pr-mCherry in SD
vacuole membrane108.76 -
N' NATIVEpr-GFP in SD

vacuole membrane48.0108 -
N' TEF2pr-VC and Cyto-VN in SD
vacuole membrane33.9258 -
C’ GFP library in SD+DTT

ER35.430.79No -
C’ GFP library in SD+H2O2
ER56.231.26No -
C’ GFP library in Starvation Media

ER25.410.57Yes -
C’ GFP library on the background of Pup2-DaMP

ER -
C’ GFP library on the background of CCT mutant

ER34.46050.774948No
